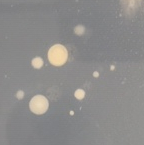

Microbial Physiology
Microbes and dissolved organic matter
The oceans are the largest habitat on earth, covering 70% of the planet. While much of the ocean may seem to be empty of life, there is a great deal of life and activity in a drop of water if you look at it on a micro scale. Marine microbes are responsible for half of the oxygen production on the planet and influence global-scale processes like carbon cycling. In most of the ocean however, primary production that captures carbon dioxide, is limited by inorganic nutrients, typically nitrogen or phosphorus or both. Therefore, it is important to understand how microbes respond to nutrient limitation so we can use this information to better inform models of global carbon cycling.
My postdoctoral research in the Kujawinski Lab at Woods Hole Oceanographic Institution (WHOI) included several projects on marine bacteria, archaea, and algae. Major outcomes of this work include 1) identification of novel mechanisms of microbe-DOM interactions by Cyanobacteria (Fiore et al. 2015) and 2) identification of a gene that encodes for a transcription factor in marine phytoplankton (paper has been published!)) that may coordinate the physiological response to nutrient limitation. At ASU, I am working with several undergraduate students to better understand what this gene does, using the model freshwater alga, Chlamydomonas reinhardtii. This organism is easy to culture and can provide insights into the role of this gene in algae. Additionally, this gene may be a useful target for biofuel engineering as it has a role in the accumulation of triglycerides or oil, which is a common response to nutrient stress in algae.

Part of the motivation behind the work that led to the discovery of the novel transcription factor in marine algae was to better understand how microbes access and alter a major nutrient pool called dissolved organic matter (DOM). I am interested in how microbes influence the composition of this DOM, which can then influence which other organisms can survive in a given habitat. Part of the DOM pool is made up of “small” molecules, many of which are metabolites such as vitamins, nucleotides, and amino acids. Most microbes release some compounds (amino acids, etc.) to the environment, adding to the DOM pool, and remove other nutrients that they use for energy or growth. For most microbes, we do not know what types of compounds they add to the environment and what types they remove. In collaboration with the Kujawinski laboratory at WHOI, I am interested in finding out how microbes alter the composition of DOM and what this can tell us about the ecology and physiology of the microbes themselves.
Aside from free-living microbes, host-associated microbes in sponges can access and modify DOM in seawater. The results of a recent project that I led in the Kujawinski lab have indicated that sponge holobionts can alter the composition of DOM with potential impacts on nutrient availability for other organisms on the coral reef (see nutrient cycling)
Mechanism of bioluminescence in marine dinoflagellates

In collaboration with Mark Venable at ASU, I and several undergraduate students are investigating an elusive mechanoreceptor on the cell surface of dinoflagellates, a type of marine alga. Dinoflagellates are known for their bioluminescence – if you have seen bioluminescence in the ocean from waves or boats or swimmers this is likely from dinoflagellates. These unicellular algae luminesce in response to physical pressure or shear stress, likely a survival strategy meant to scare predators away. There are also mechanoreceptors in humans involved in sensing touch, pressure, and vibration, but they are not well characterized. We are using molecular techniques to identify and understand mechanoreceptors in dinoflagellates as the bioluminescence is a clear signal to tell us if we have disrupted a protein in the pathway. We obtained internal funding to support this project and students have presented their work at the Association of Southeastern Biologists annual meeting.
Biogas production with marine algae

In collaboration with the Mark Venable in biology and Mike Hambourger in chemistry, we are in the early stages of investigating the use marine algae for biogas production. Our goal is to test multiple parameters at a small scale to optimize biogas production and then ideally bring this up to a usable scale for a coastal city or town.